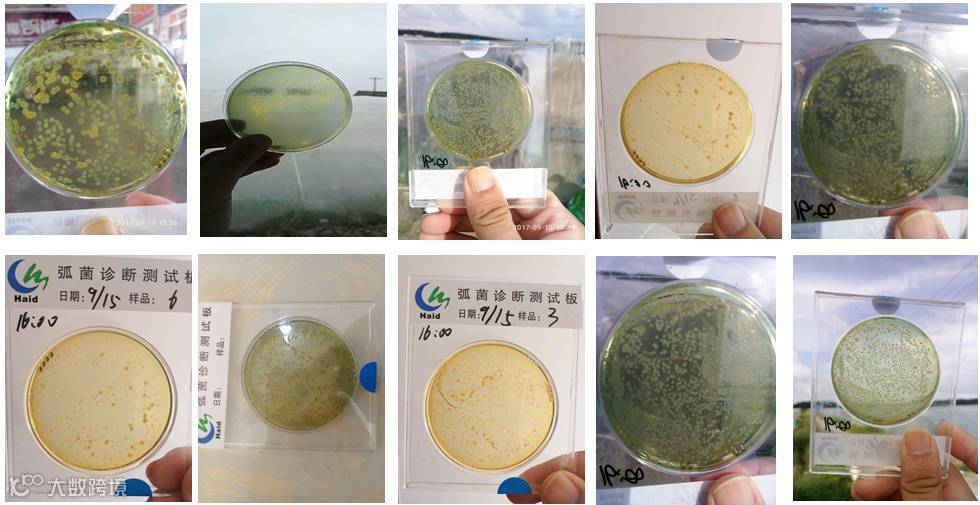

文 | 图 南通海大 刘广思 施荣
一、小棚目前养殖问题
如东秋虾养殖,大多七月底、八月初放苗,高温为主,持续高温,虾摄食旺盛,投喂量不断增加。如今经过一个月的养殖,虾塘中的残饵、粪便积累,加速底质恶化,同时高温期易使水体分层,造成底层缺氧,底质黑臭。这些极易导致弧菌滋生,侵染对虾,继而引起发病,对虾摄食减慢,肝胰脏发红、溃烂,出现空肠空胃,不然后出现大量死虾,造成排塘。给养殖户造成巨大的损失。

图1 弧菌爆发引发的白虾突然大量偷死
二、养殖关键期,预防弧菌偷死
9月是小棚养殖的病害高发期,突发性偷死问题刺痛着养殖户的神经,特定苗种,特定养殖阶段,毫无征兆的发现零星死虾,接着大量死亡,让很多客户猝不及防。海大服务部通过跟踪、测试大量的养殖塘口,弧菌检出率较高,现阶段小棚发病率也比较严重,我们建议养殖到30至40天时,使用海联科靓底集中消毒一次,预防弧菌,增加养殖成功率。
图2 养殖30天以上小棚弧菌检测结果
三、具体案例
老坝港客户蔡老板,7月30号放苗,9月中旬单棚投喂12斤料/棚,养殖一切正常,9月14号突然发现有掉苗,虾摄食减慢, 而水色也发生了转变。
进行弧菌涂板检测后,发现水体里有大量黄绿弧菌,随即使用靓底半包一个棚,4小时后虾多宝发酵液15斤一个棚。9月16号取样涂板检测后发现弧菌数量大大减少,目前偷死已经停止,白虾摄食已经恢复到10斤/天。

海联科靓底,正宗高含量过硫酸氢钾,克制弧菌不含糊
小结
在养殖过程中,随着底部有机物积累,耗氧微生物繁殖加快,导致底部缺氧环境,极易滋生弧菌。尤其是在雨后转晴的天气,温度骤升、底部溶氧降低,给弧菌提供了适宜的生长环境,引起弧菌爆发。
1、养殖一个月后,选择晴天上午,或虾出现黑斑、红爪、红尾现象时使用靓底1包/2棚进行消毒。
2、3到6小时后补充有益菌群(虾多宝发酵液20斤每棚)。虾多宝发酵液中含有大量的有益活菌,又具有非常好的稳水效果。
使用消毒剂后,池塘菌类数量巨减,生长空间释放出来。此时应大量补充有益菌群,抢占先机,快速建立有助于改良底质、促进物质循环、抑制有害菌爆发的有益菌群,发挥优势种群作用和拮抗作用,防止弧菌滋生和繁殖。
➤ 海大服务部温馨提示:
9月中旬以后,小棚水色需以浓为佳,水色掉清容易出现偷死等问题,可通过101+育藻膏泡肥适当进行补肥操作;在弧菌预防上,苗期以泼洒发酵液为主,干拌为辅。养殖中期,水色浑浊后,干拌虾多宝量可适当加大,有助于安全度过特定养殖阶段病害高发期;变天情况下,使用海联科202,夜间增氧底改,有效预防白虾突发性偷死问题。
论虾三剑客
论虾三剑客栏目由南通海大三位工程师施荣、沈烈书、林绍杰专为南通如东小棚养殖模式、山东工厂化养殖模式、外塘养殖模式所打造。主要服务于江苏、山东广大南美白对虾养殖户。
虽然养殖技术有相通性,但提醒其他地区和不同模式的养殖户,本文仅供参考,请结合本地特点进行实际应用。

论虾三剑客内容精彩


